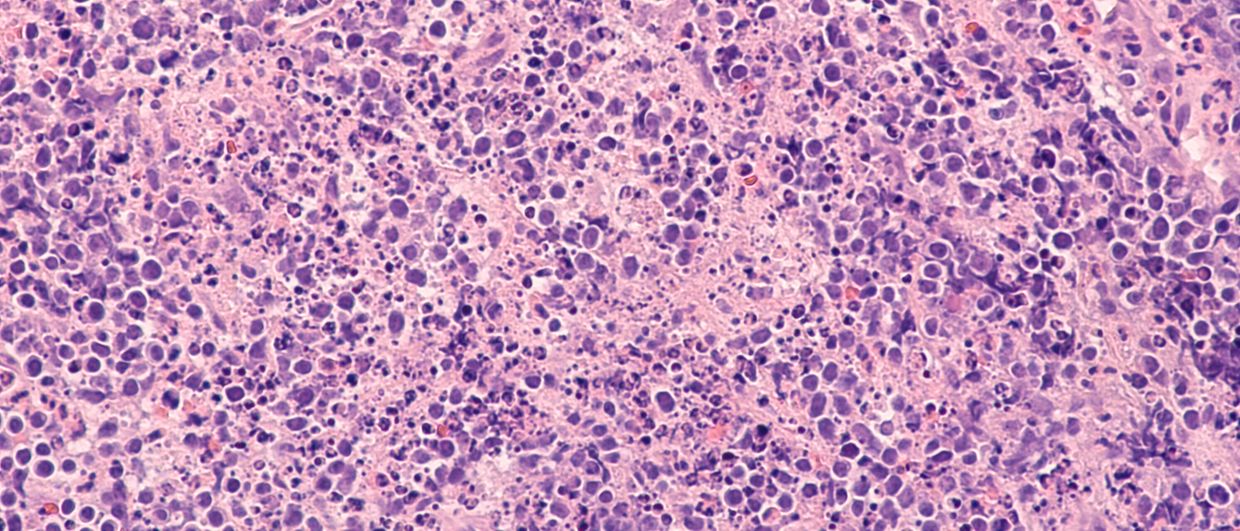

Informationen zum Kurs
Lehrziel:
Dieses Videolearning vermittelt umfassende Information zum diffusen großzelligen B-Zell-Lymphom (DLBCL). Teil 1 fasst den Wissensstand in der Diagnostik sowie in der Erstlinientherapie zusammen, Teil 2 erläutert die Optionen in den nachfolgenden Therapielinien.
Primäre Zielgruppe(n):
Onkologen, Hämatologen
Wissenschaftlicher Leiter:
Univ.-Prof. Dr. Peter Neumeister
Klinische Abteilung für Hämatologie
Medizinische Universität Graz
Vortragende:
Priv.-Doz.in DDr.in Katharina Prochazka
Klinische Abteilung für Hämatologie
Medizinische Universität Graz
OÄ Dr.in Barbara Uhl
Abteilung für Innere Medizin
Bezirkskrankenhaus Lienz
DFP-Punkte:
Für die richtige Beantwortung der Multiple-Choice-Fragen werden 2 Punkte für das Diplom-Fortbildungs-Programm der Österreichischen Ärztekammer zuerkannt.
Fachbereich:
Onkologie, Hämatologie
Lecture Board:
Prim. Univ.-Prof. Dr. Felix Keil
3. Medizinische Abteilung
Hanusch-Krankenhaus, Wien
Priv.-Doz. Dr. Wolfgang Willenbacher
Universitätsklinik für Innere Medizin V Innsbruck
Schwerpunkte: Hämatologie und Internistische Onkologie
Tirol Kliniken, Innsbruck
Ärztlicher Fortbildungsanbieter:
Gesellschaft der Ärzte
Organisation:
Universimed Cross Media Content GmbH
Kosten:
Dieser Kurs wird Ihnen kostenlos zur Verfügung gestellt.
Offenlegungsstatement:
Alle Personen, die bei diesem Kurs vortragen bzw. an den Inhalten mitgewirkt haben, wurden aufgefordert, eventuell bestehende Interessenkonflikte offenzulegen, die mit einer Beeinflussung der Lehrinhalte einhergehen könnten.
Sponsor:
INCYTE Biosciences Austria GmbH
Gültig bis:
Mai 2026